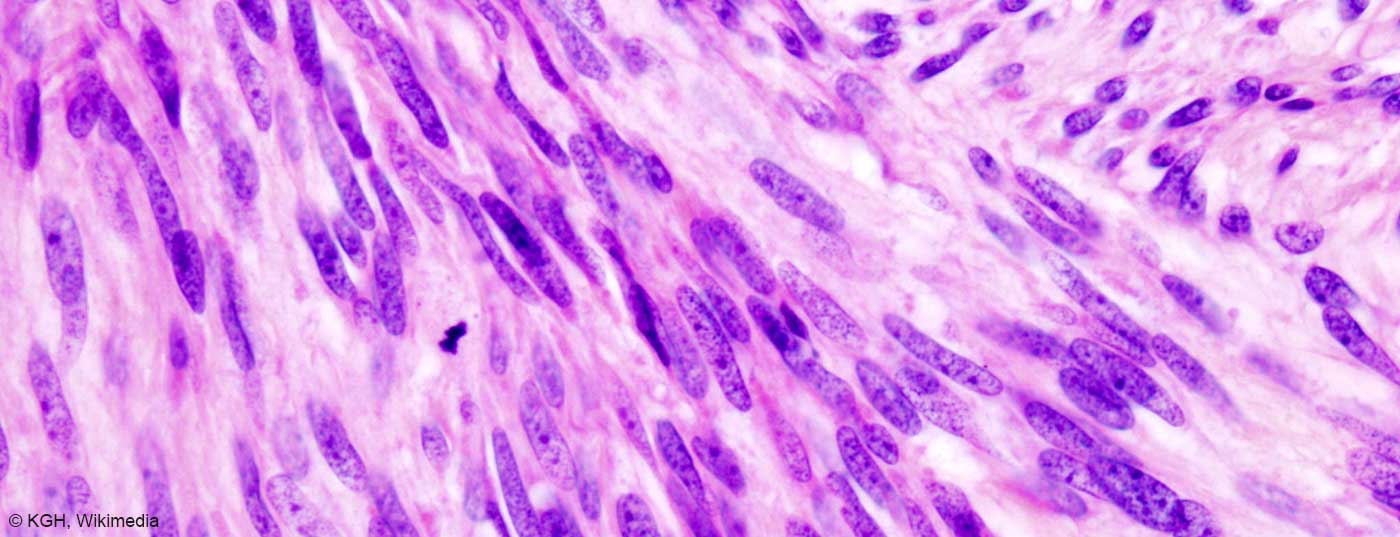
gist_gastric

GIST finden sich am häufigsten im Magen und im Dünndarm. Eine neue umfassende Analyse der US-amerikanischen SEER-Datenbank (Surveillance, Epidemiology, and End Results) zeigt: Entgegen dem verbreiteten Dogma ist die Prognose bei Patienten, die GIST des Dünndarms aufweisen, nicht schlechter als bei Personen mit GIST des Magens. Was bedeutet diese Erkenntnis für die Behandlung der entsprechenden Tumoren?